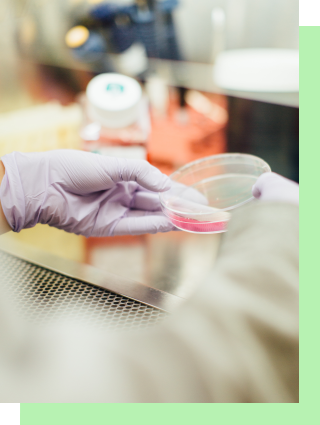
Research & development image

ABOUT US
We created THR1VE to transform the health and wellness of all Australians, through the delicious simplicity of real food nutrition and an active lifestyle.


Like so many other nations around the world, Australians are suffering from a variety of so called 'lifestyle diseases' in unprecedented numbers. We use many different words to describe these conditions - overweight and obese, chronic inflammation, type 2 diabetes, and so on – but the root causes are all overwhelmingly diet and activity related.
These illnesses create a staggering cost to human health, happiness and productivity, while placing an enormous and unsustainable strain on our cherished universal healthcare system. Reactively treating chronic disease simply won't solve the problem, indeed it continues to worsen. So we challenged ourselves to think differently, to create innovative and proactive solutions to the lifestyle disease crisis.
We are committed to providing real world solutions – ideally preventing lifestyle disease in the first place, and also assisting those already burdened with these illnesses with natural options to support their healing.
HOW DO WE DO IT?

Nutrition solutions
We create real food ready meals and bespoke supplements, designed by nutritionists and chefs who work collaboratively. Our nutrition solutions are based on the latest science and help our customers lose excess bodyweight, reduce inflammation, improve fitness and recovery from exercise, and enhance mental and emotional performance.
Lifestyle programs
We provide the THR1VE Protocol, an 8-week lifestyle program consisting of a nutrition plan and training program designed as a true intervention. It 'resets' the metabolism, breaks bad habits and creates empowering alternatives, educating customers on smart plate design and serving size, and greatly accelerates progress towards optimum health and wellness.

Research & development
We invest in world-first, university-led nutritional research and work with third-party researchers around the world to constantly improve our offer based on the latest scientific breakthroughs.
WHY THR1VE?
We are the real deal, our nutrition solutions are efficient, effective and sustainable, and we have the third party validation and scientific proof to back that up.
Whether you choose to follow the intensive 8-week nutrition and training intervention, or simply use the THR1VE ready meals and supplements as a trusted ‘go-to' to support your goals when a shortage of time puts good decisions at risk, you can be assured that we have done the hard work so you don't have to.

You deserve a partner in health and wellness that takes your goals and objectives just as seriously as you do, without compromising on taste, convenience or value for money.
THR1VE has your back.

